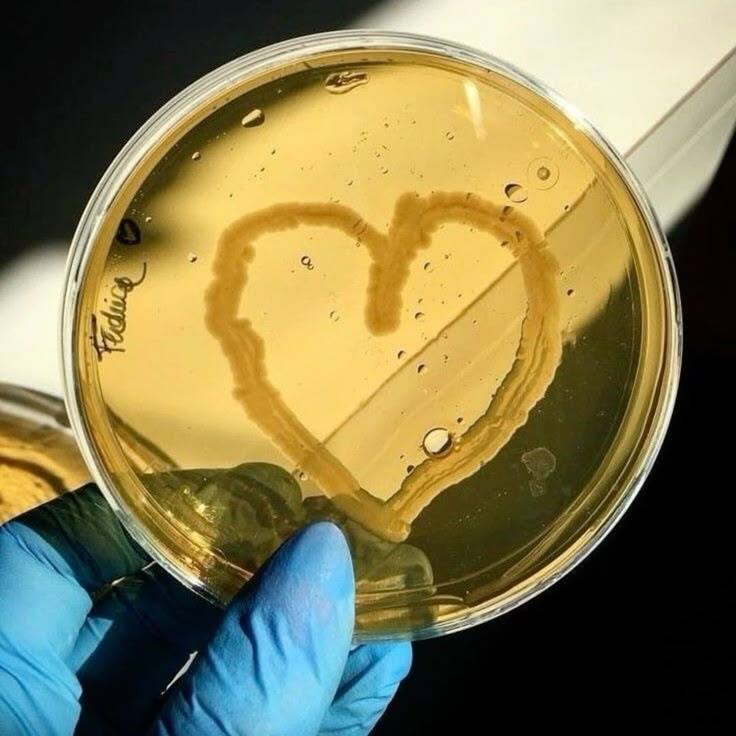

Профессия
зарплата от 80 000 ₽ в месяц
Нутрициолог





Нутрициолог — это специалист по питанию, который помогает людям правильно выстраивать рацион, улучшать пищевые привычки и поддерживать здоровье. В отличие от диетолога (который работает с медицинскими диагнозами), нутрициолог чаще фокусируется на профилактике, коррекции веса, подборе индивидуального питания и детоксе.
Чем занимается нутрициолог?
Нутрициолог - востребованная профессия
Профессия подойдёт тебе, если
Ниши, которые ты можешь выбрать
Программы


от 2 500 ₽
от 80 000 ₽
средняя зарплата нутрициолога
от 6 мес
занимает обучение
стоит часовая консультация
Тебе интересна и близка тема ЗОЖ
Спортивное питание
Женская нутрициология
Рационы для стройности
Кишечник микробиома
Рацион для стройности
У тебя есть медицинское
образование
образование
Ты сама преодалела трудности в сфере питания
Нутрициология - очень
обширная и глубокая отрасль,
требующая погружения
и вовлечённости, тк придётся
очень много учиться.
обширная и глубокая отрасль,
требующая погружения
и вовлечённости, тк придётся
очень много учиться.
Один из главных секретов успеха - это выбрать "свою" нишу и постоянно углубляться и совершенствоваться в ней. Благо в нутрициологии выбор ниш очень широкий: от составления рационов для спортсменов до псхологии питания, выбирай, что тебе по душе
Фокусируется на оптимизации рациона для роста мышц, восстановления и повышения выносливости, используя протеины, БАДы и индивидуальные планы под нагрузки.
Учитывает гормональные циклы, беременность и менопаузу, подбирая рационы для баланса эстрогена, энергии и профилактики анемии.
Создает основы здоровых привычек у детей, решает проблемы аллергий, прикорма
и питания школьников, предотвращая дефициты витаминов.
и питания школьников, предотвращая дефициты витаминов.
Детская нутрициология
Психология питания
Работает с эмоциональным перееданием, РПП и пищевыми зависимостями, помогая выстроить гармоничные отношения с едой через осознанность.
Помогает снижать вес через баланс калорий, контроль порций и подбор продуктов, сохраняя энергию и ускоряя метаболизм без жестких диет.
Изучает связь микрофлоры ЖКТ с иммунитетом, настроением и весом, корректируя питание пробиотиками и клетчаткой для здоровья «второго мозга».
Конкуренция сейчас достаточно высокая и высшее образование в
сфере здравоохранения станет очень большим конкурентным приемуществом.
сфере здравоохранения станет очень большим конкурентным приемуществом.
Собственный опыт преодаления проблем, с которыми сталкиваются клиенты, позволит тебе проявляться более эмпатично и быстрее завоёвывать авторитет и доверие.

Бесплатный курс
Курс позволяет бесплатно прикоснуться к профессии нутрициолога, чтобы понять для себя, подходит он вам или нет. Преподаватели курса - практикующие врачи.
1 Урок: Работа нутрициолога
2 Урок Методики работы нутрициолога
3 Урок Дефициты витаминов
4 Урок Инсулинорезестентность и ожирение
5 Урок Диагностика базовых анализов
1 Урок: Работа нутрициолога
2 Урок Методики работы нутрициолога
3 Урок Дефициты витаминов
4 Урок Инсулинорезестентность и ожирение
5 Урок Диагностика базовых анализов
Бесплатный курс
С помощью бесплатного Telegram-бота познакомитесь с профессией нутрициолога, выполните рабочие задачи специалиста и получите шаблоны консультаций
- Узнаешь, с какими запросами обращаются к нутрициологу
- Самостоятельно попробуешь решить реальную рабочую задачу
- Познакомишься с основными инструментами
8 250 ₽/мес
в рассрочку на 24 месяца
Популярный курс
Курс ведут преподаватели - доктора и кандидаты медицинских наук. При окончания курса выдаётся 2 диплома: диплом от Skillbox и диплом о профессиональной переподготовке МГМУ им. И. М. Сеченова. В курсе большой упор делается на научный подход.
* Бонусный курс: "Стратегия развития личного бренда"
- Основы нутрициологии
- Роль питания в обеспечении и поддержке ресурсов организма
- Основы практической деятельности: основные подходы к построению персонализированного рациона
- Роль питания при профилактике и коррекции аллиминатрно-зависимых и некоторых других заболеваниях
- Особенности питания в разные возрастные периоды и в разных состояниях
- Нейронутрициология и здоровье мозга
- Дефицитные состояния и растройства пищевого поведения
- Психология здоровья
- Итоговая аттестация
* Бонусный курс: "Стратегия развития личного бренда"
8 250 ₽/мес
Научитесь создавать программы питания с опорой на современные научные данные
Усилите личный бренд и начнёте работать с клиентами уже в процессе обучения
* Предусмотрены индивидуальные встречи с ментором
Усилите личный бренд и начнёте работать с клиентами уже в процессе обучения
- Профессия нутрициолог
- Основы анатомии и физиологии
- Основы здорового питания
- Дефициты в организме
- Психология пищевого поведения
- Образ жизни
- Технологии работы с клиентом
- Нутрициология для детей и подростков
- Развитие личного бренда и привлечение клиентов
- Дипломная работа
* Предусмотрены индивидуальные встречи с ментором
от 2 450 ₽/мес
от 8 350 ₽/мес
в рассрочку на 24 месяца
в рассрочку на 24 месяца
Популярные статьи